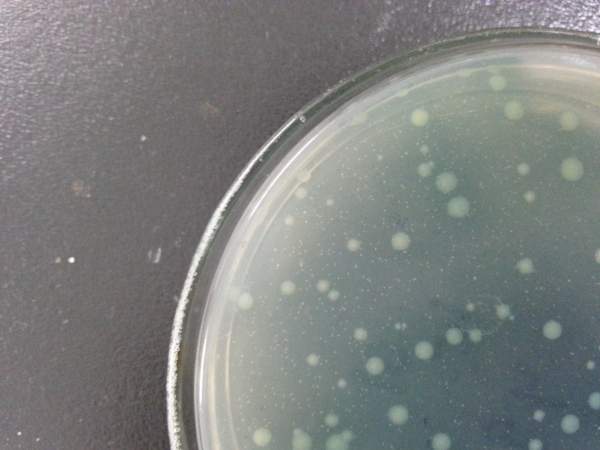

菌肥这么火,为啥很多用户说没效果?
来源:唐氏化工 编辑:admin 时间:2019-06-13 16:14

近几年菌肥火热,2018年我国微生物肥料登记呈井喷式增长,产能达到3000万吨。土壤问题日益突出、国家减肥增效的实施,都标志着绿色健康种植时代的来临,微生物肥料长期向好毋庸置疑。
但是,为啥很多农户反馈菌肥没效果呢?如何正确看待菌肥质量、客观评价菌肥的使用效果,并如何保证菌肥的功能得到准确实现呢?
01
为什么很多用户反映菌肥没有效果?
为什么很多用户反映菌肥没有效果?
1对菌肥的质量和效果应该有更可科学的评价和认识
菌肥是一种慢性特肥,不像速效的氮磷钾肥,使用后,一两天即可在作物长势上出现明显变化。菌肥的起效是活体的功能菌株定植到作物的根际或叶围等部位,通过其生命活动影响作物—土壤—微生物这个微环境。

其质量评价不能搞单纯的菌的数量竞赛,效果评价也不能以单一的长势为判定标准,还应该考量作物增产效果、品质改良效果、作物抗病能力及抗逆效果以及土壤理化指标的改善。
2菌肥的施用应该有更精准的应用方案指导。
菌肥不是万能的,不同的功能菌侧重点不同,菌肥的施用应该有更明确的针对性和更精确的施用方案,比如针对土壤条件、作物和病害的不同。
3市场现状决定
当前市场上的菌肥良莠不齐,质量不好的菌肥自然也起不到如其宣传所说的效果。

02
如何保证菌肥产品的效果?
要保证菌肥产品的效果,应从以下几个方面着手:如何保证菌肥产品的效果?
菌种
是菌肥的核心要素,如果菌种选择不当,所有的一切努力都是徒劳的。菌种不具备应有的功能,其菌数再高,使用到大田中不过是增加一点土壤微生物的数量而已,不会对作物产生明显的促长、防病、提质、改善土壤环境的效果。
其次生产过程中的菌种复壮
由于菌种在不断的传代过程中会出现生理遗传特性丢失等现象,必须有严格的复壮程序,保证生产菌种功能的稳定性;
最后是产品的生产工艺
不同生产工艺的产品质量是存在较大的差异。菌肥属于微生物产品,其发酵生产要保证菌种的纯度,若被其他杂菌污染,产品的效果将大打折扣。
现代发酵中深层液体发酵的技术较为成熟完善,所有发酵原料必须经过高温灭菌,使培养基处于无菌状态,待降温到规定状态,利用无菌接种技术,将功能完备、活力均一的种子接种到无菌培养基中。在人工可控的条件下完成发酵。由此生产的产品质量方能保证产品效果。
03
山东唐氏化工“幸运豆”豆粕菌肥,
用户认可的效果!
山东唐氏化工“幸运豆”豆粕菌肥,
用户认可的效果!

益生菌腐熟大豆蛋白,非转基因大豆为基础原料,深层液体发酵的技术,有益活菌数≥5.0亿/克、
具体效果怎么样,可关注山东唐氏化工有限公司微信
上一篇:果树高级栽培技术 嫁接大全
相关阅读:
- 铵态氮、硝态氮、酰胺态氮的区别及特点2024-10-11
- 苹果摘袋五忌,千万要注意!2024-10-11
- 抓好葡萄秋管,实现连年高产2024-10-11
- 有机肥是不是有机质含量越高越好?2024-05-29
- 矿源颗粒黄腐酸钾,你得这么用2024-05-29



